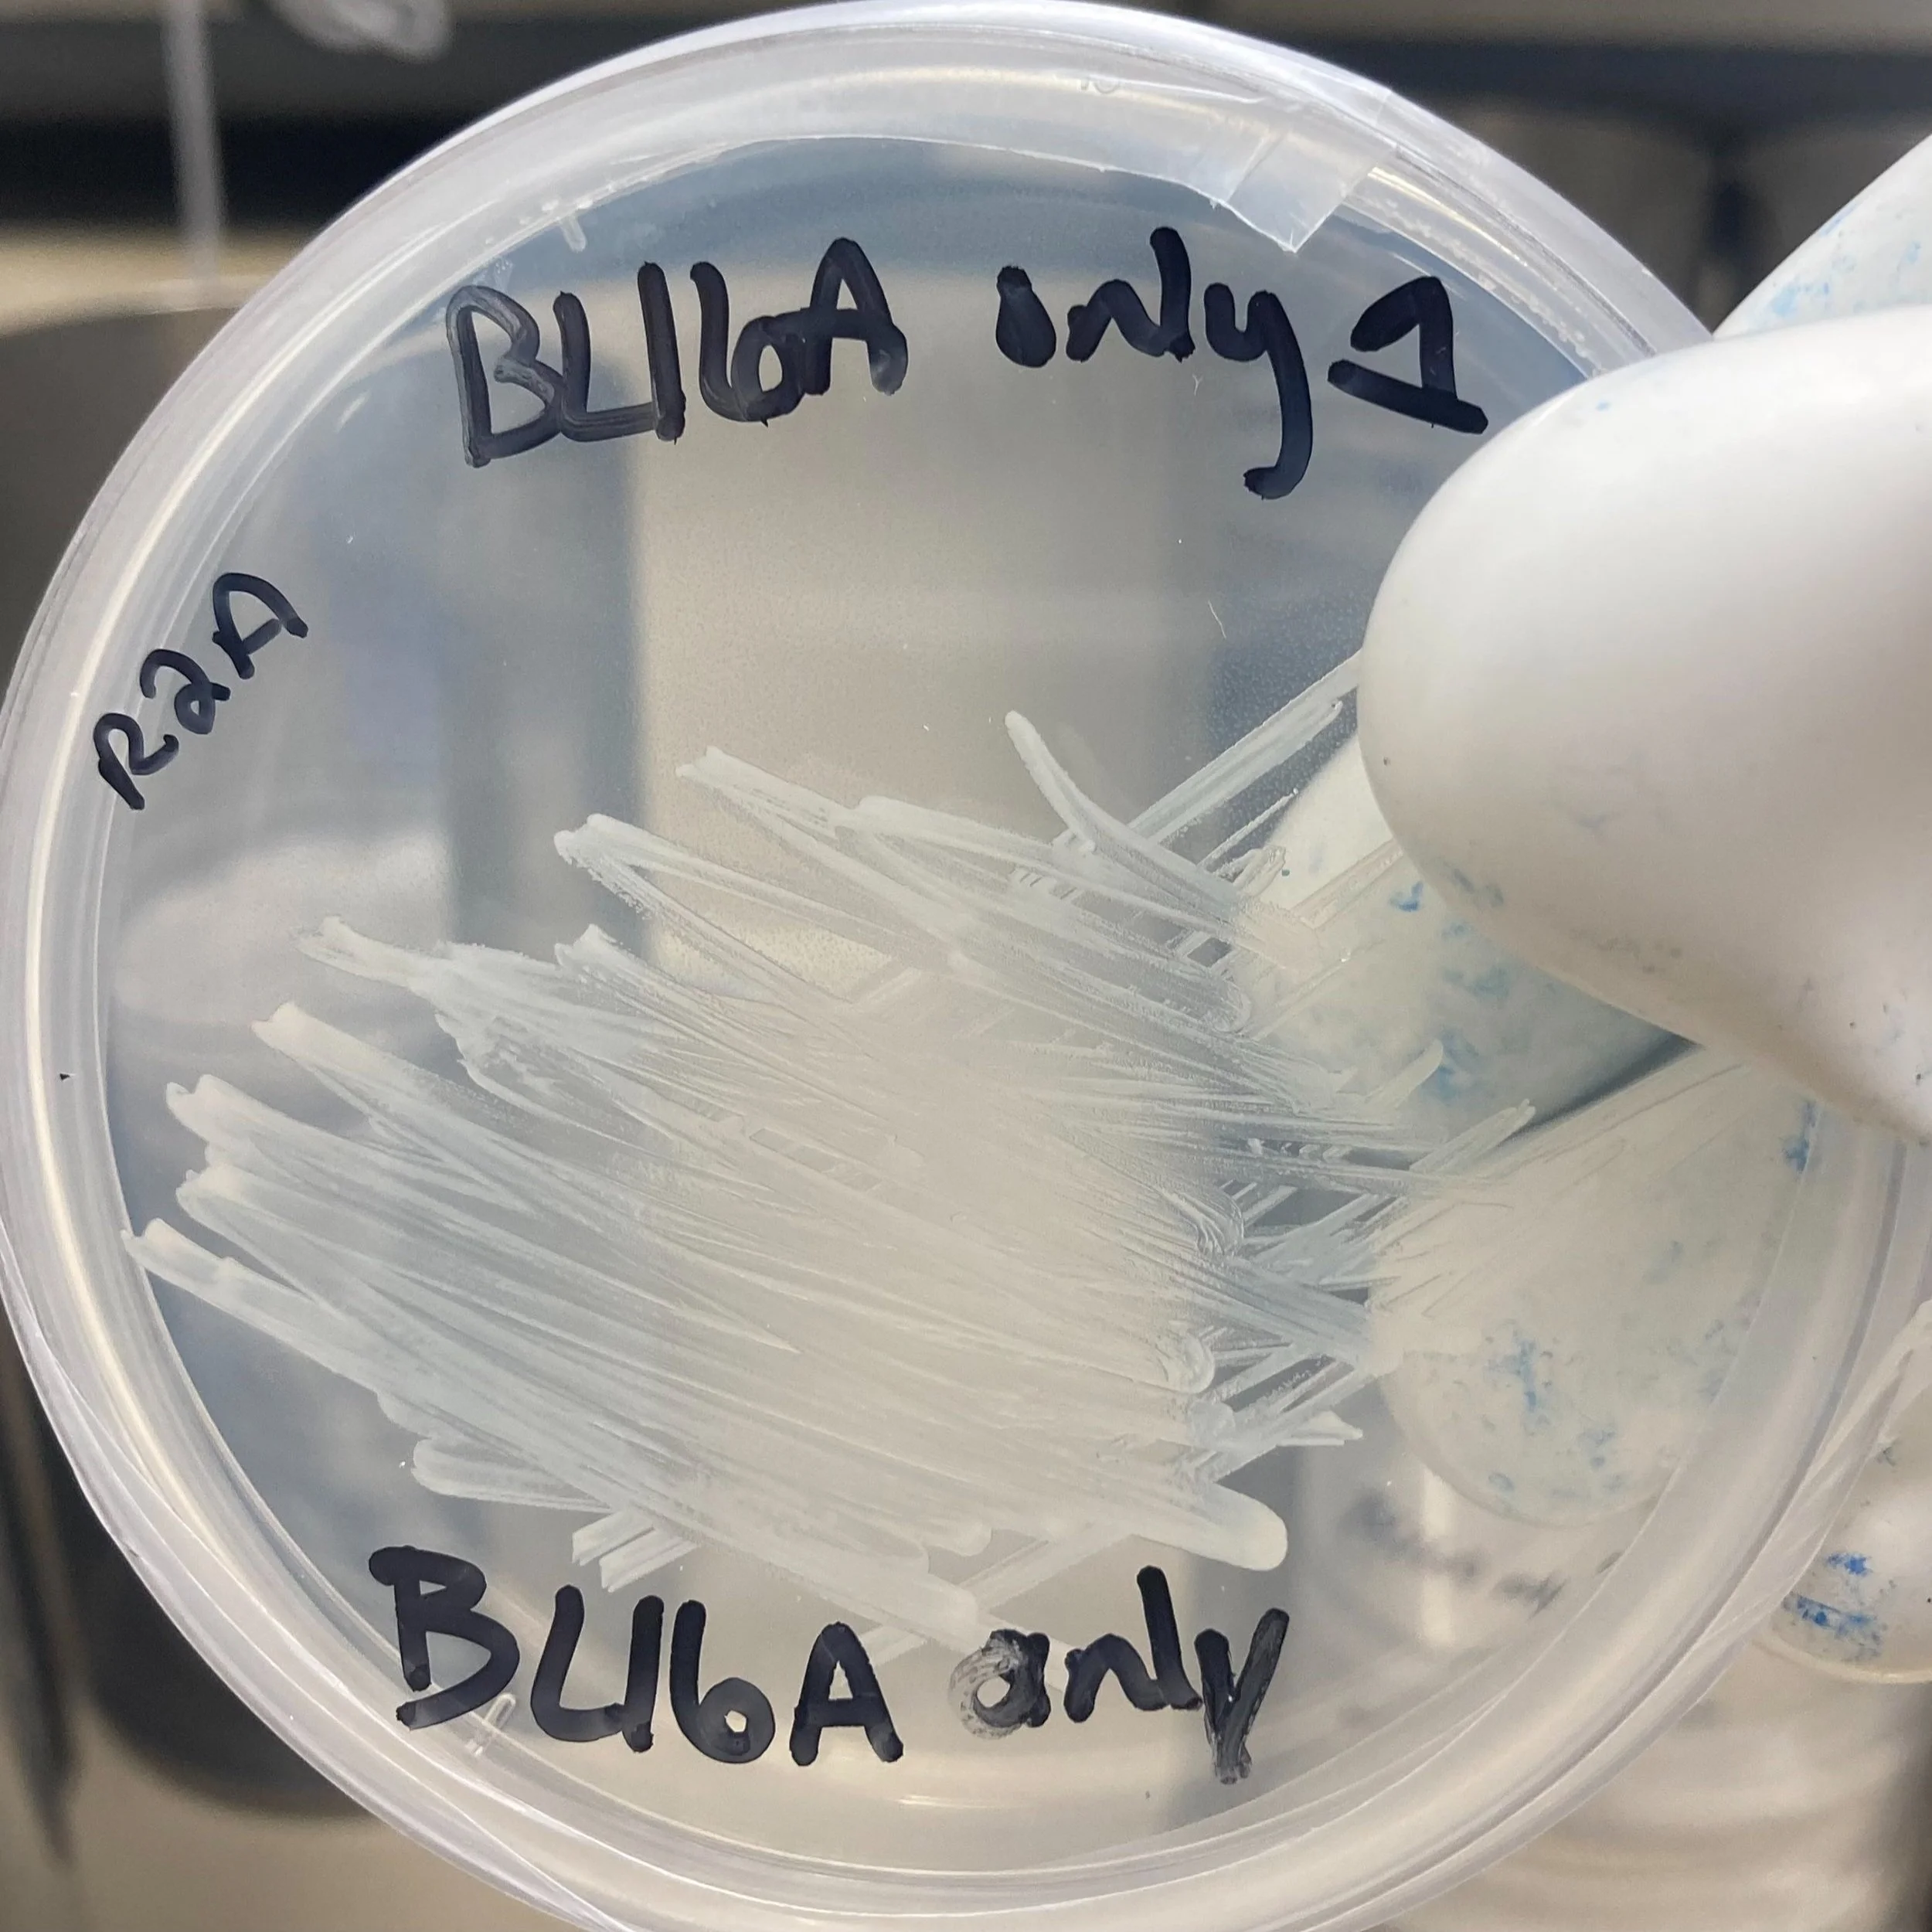
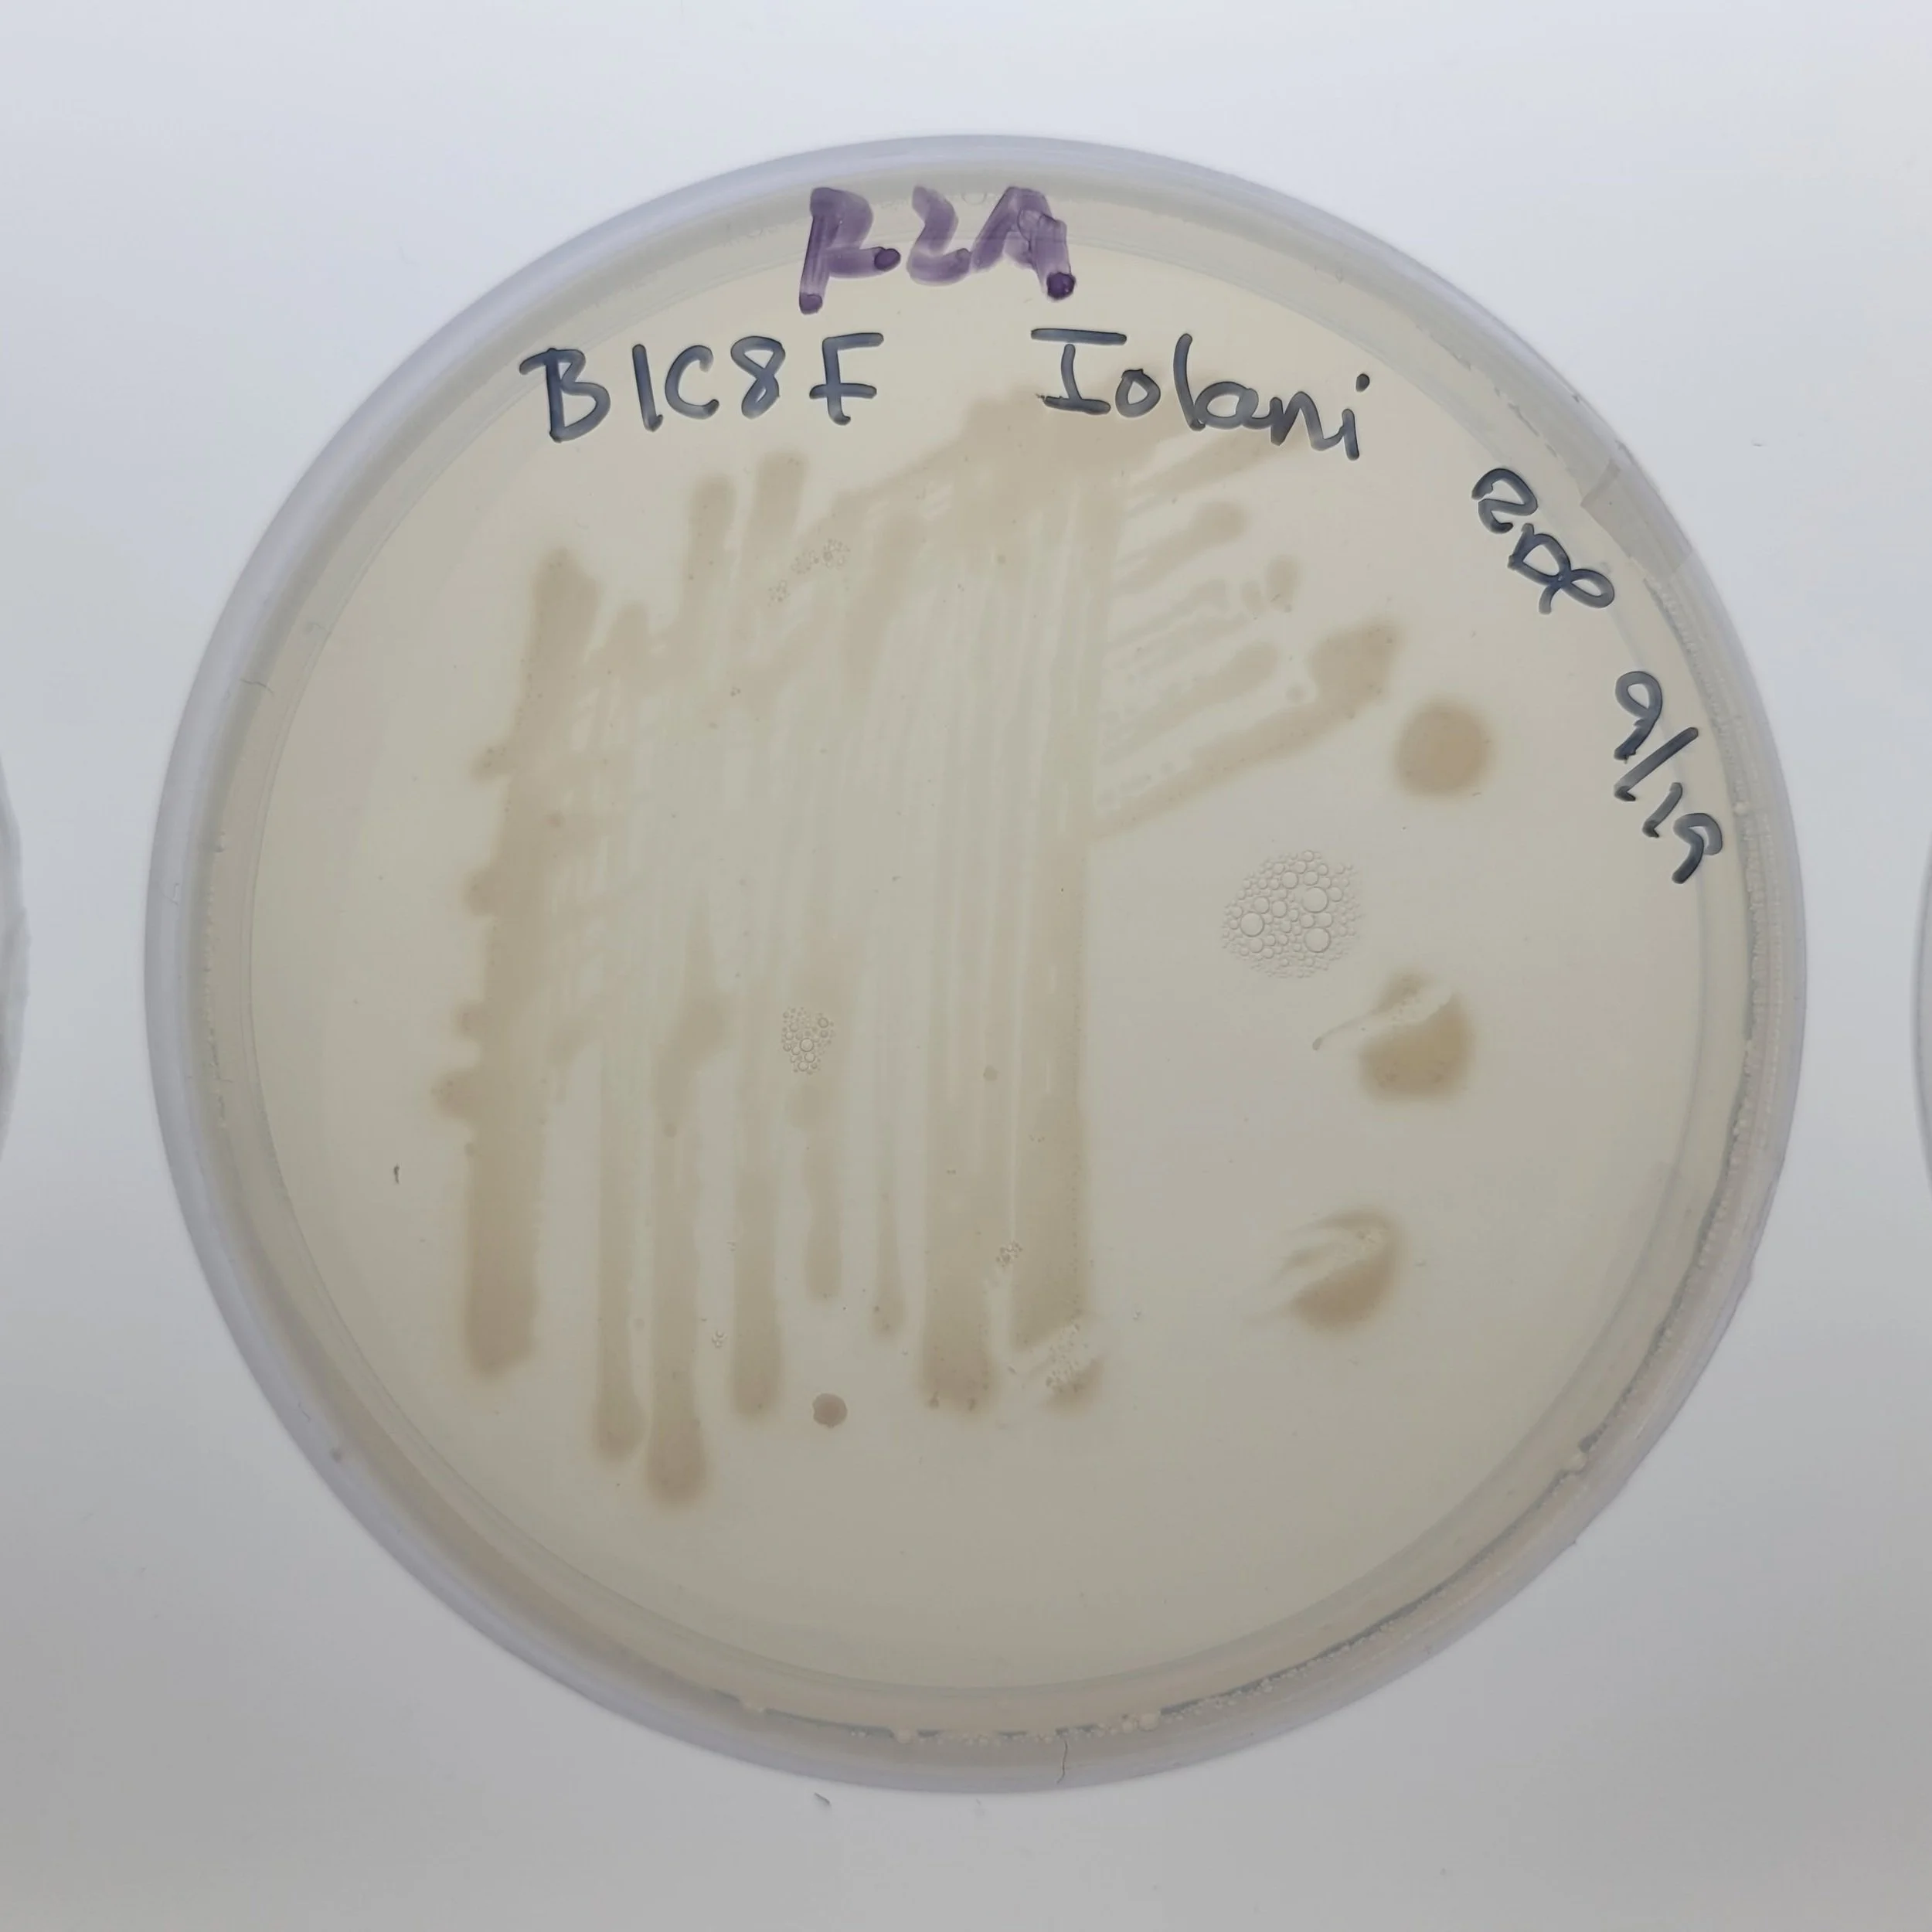
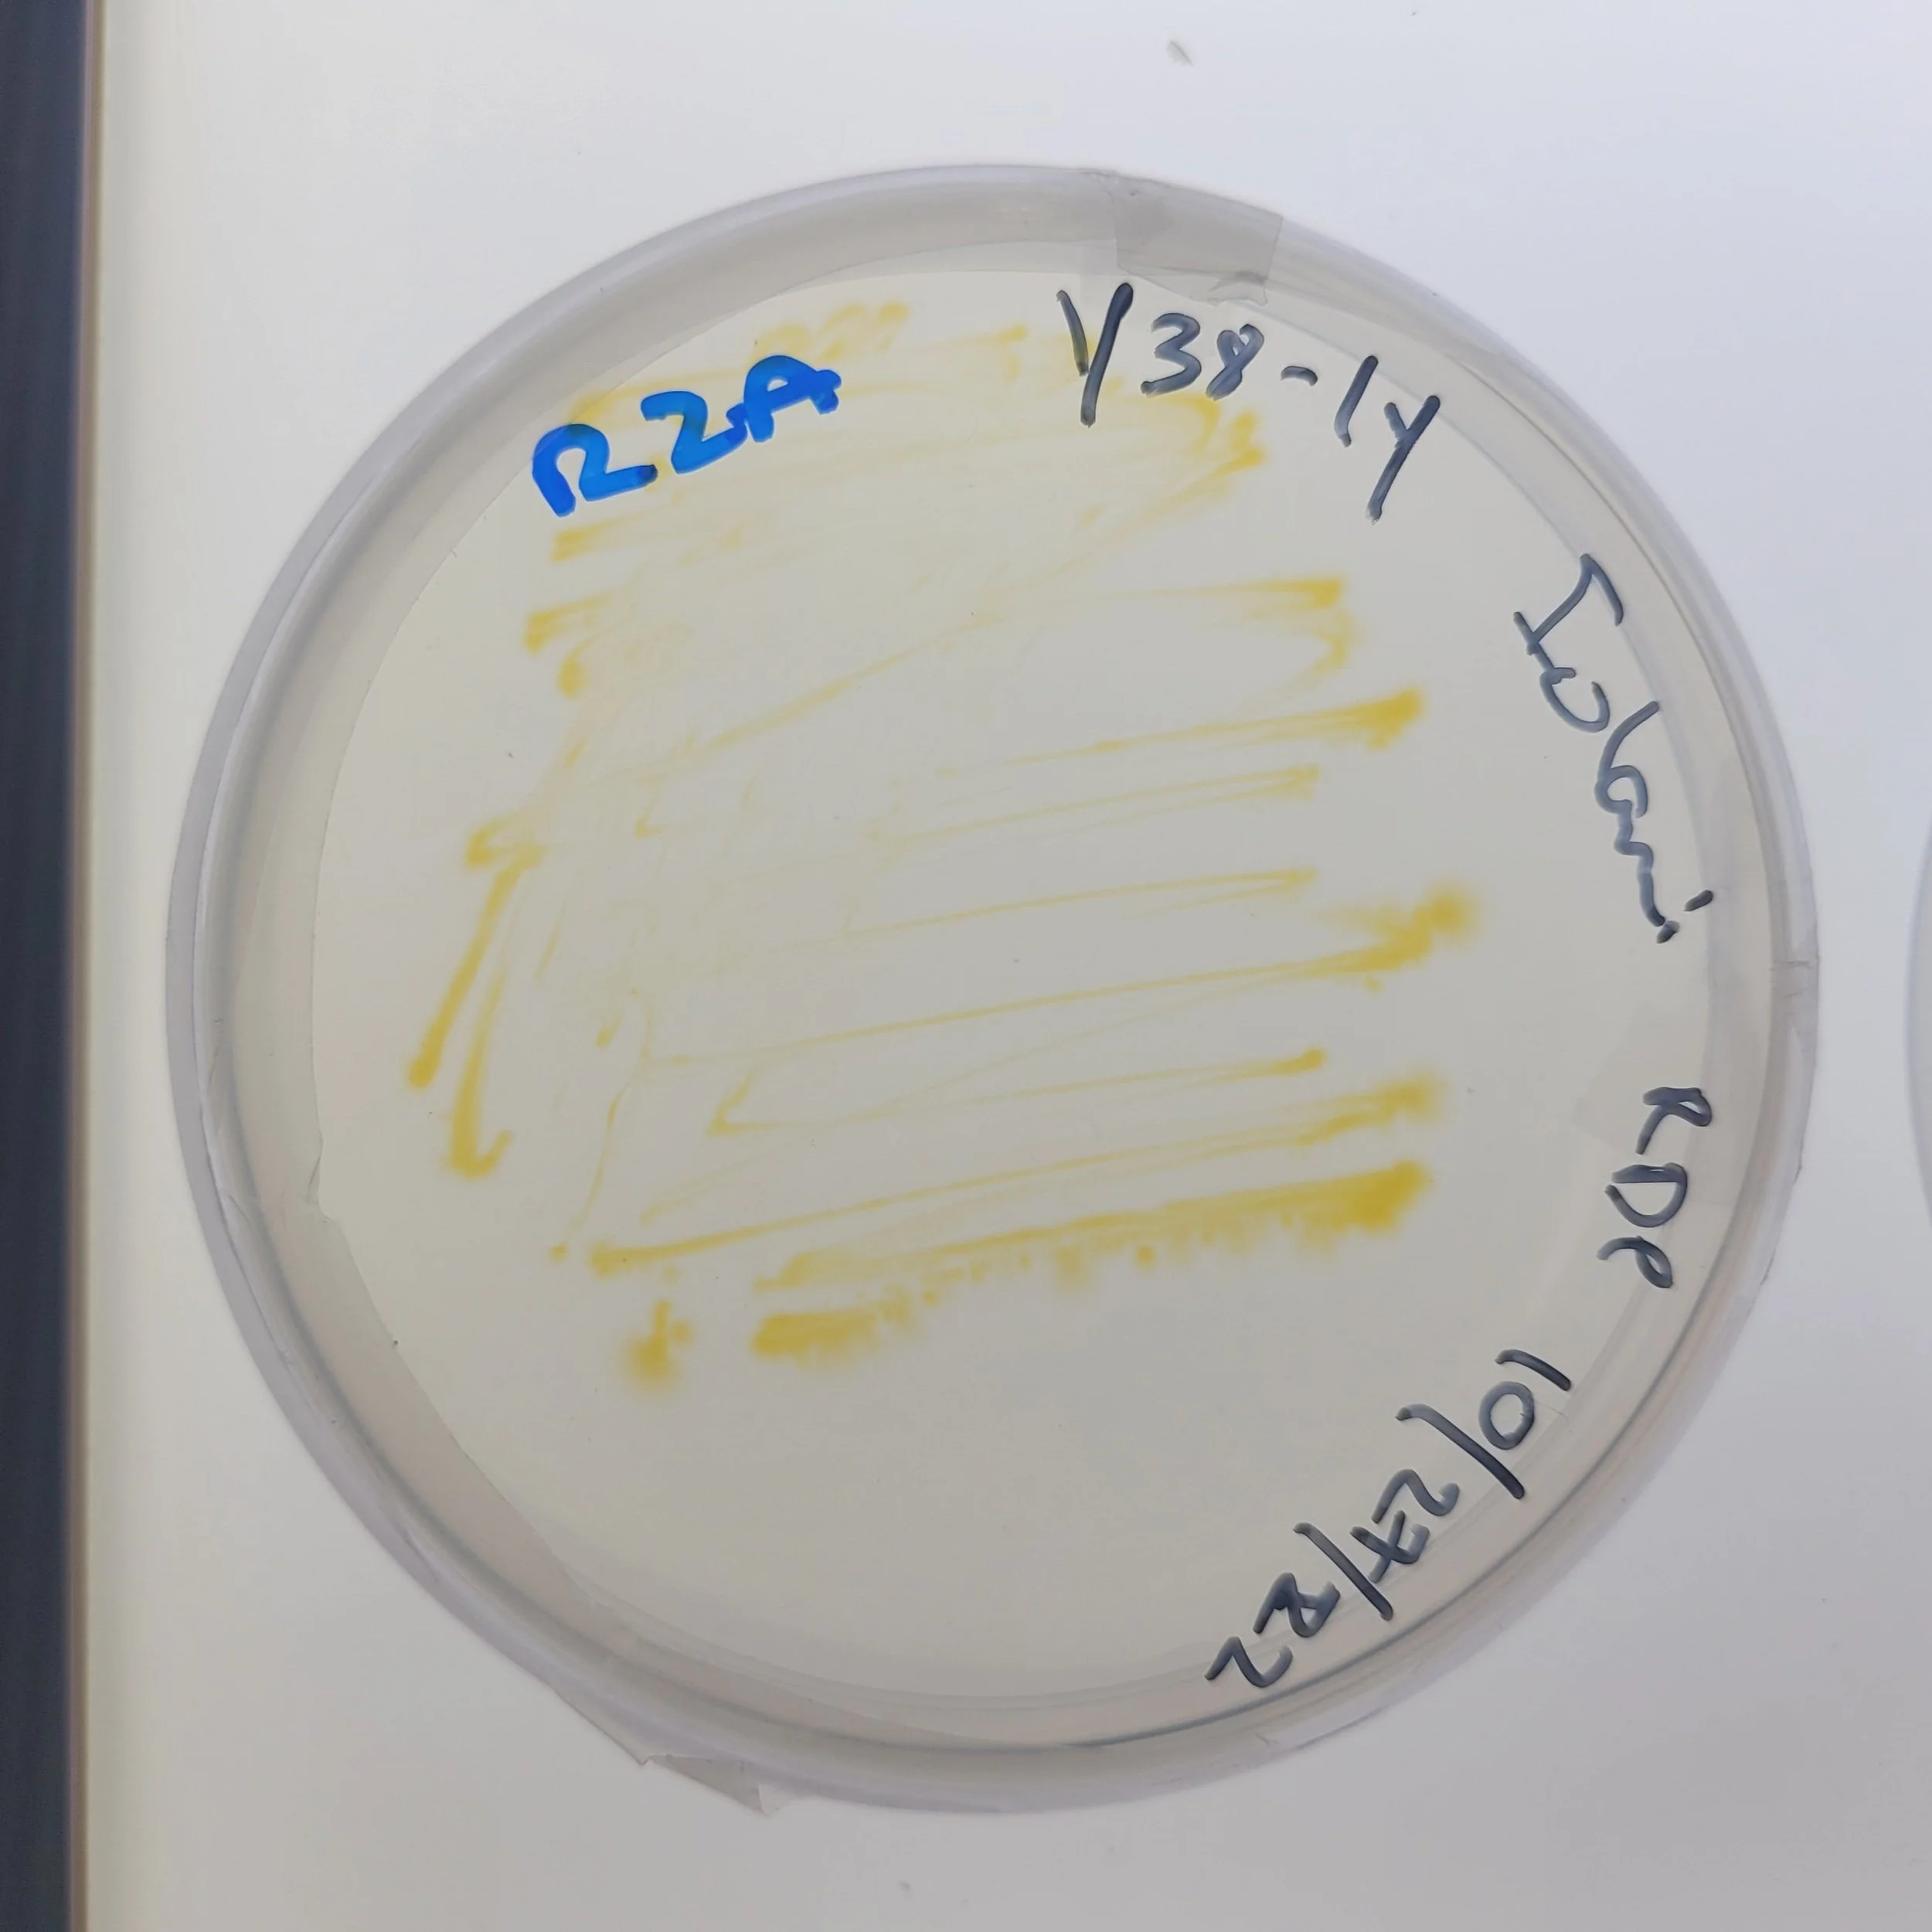
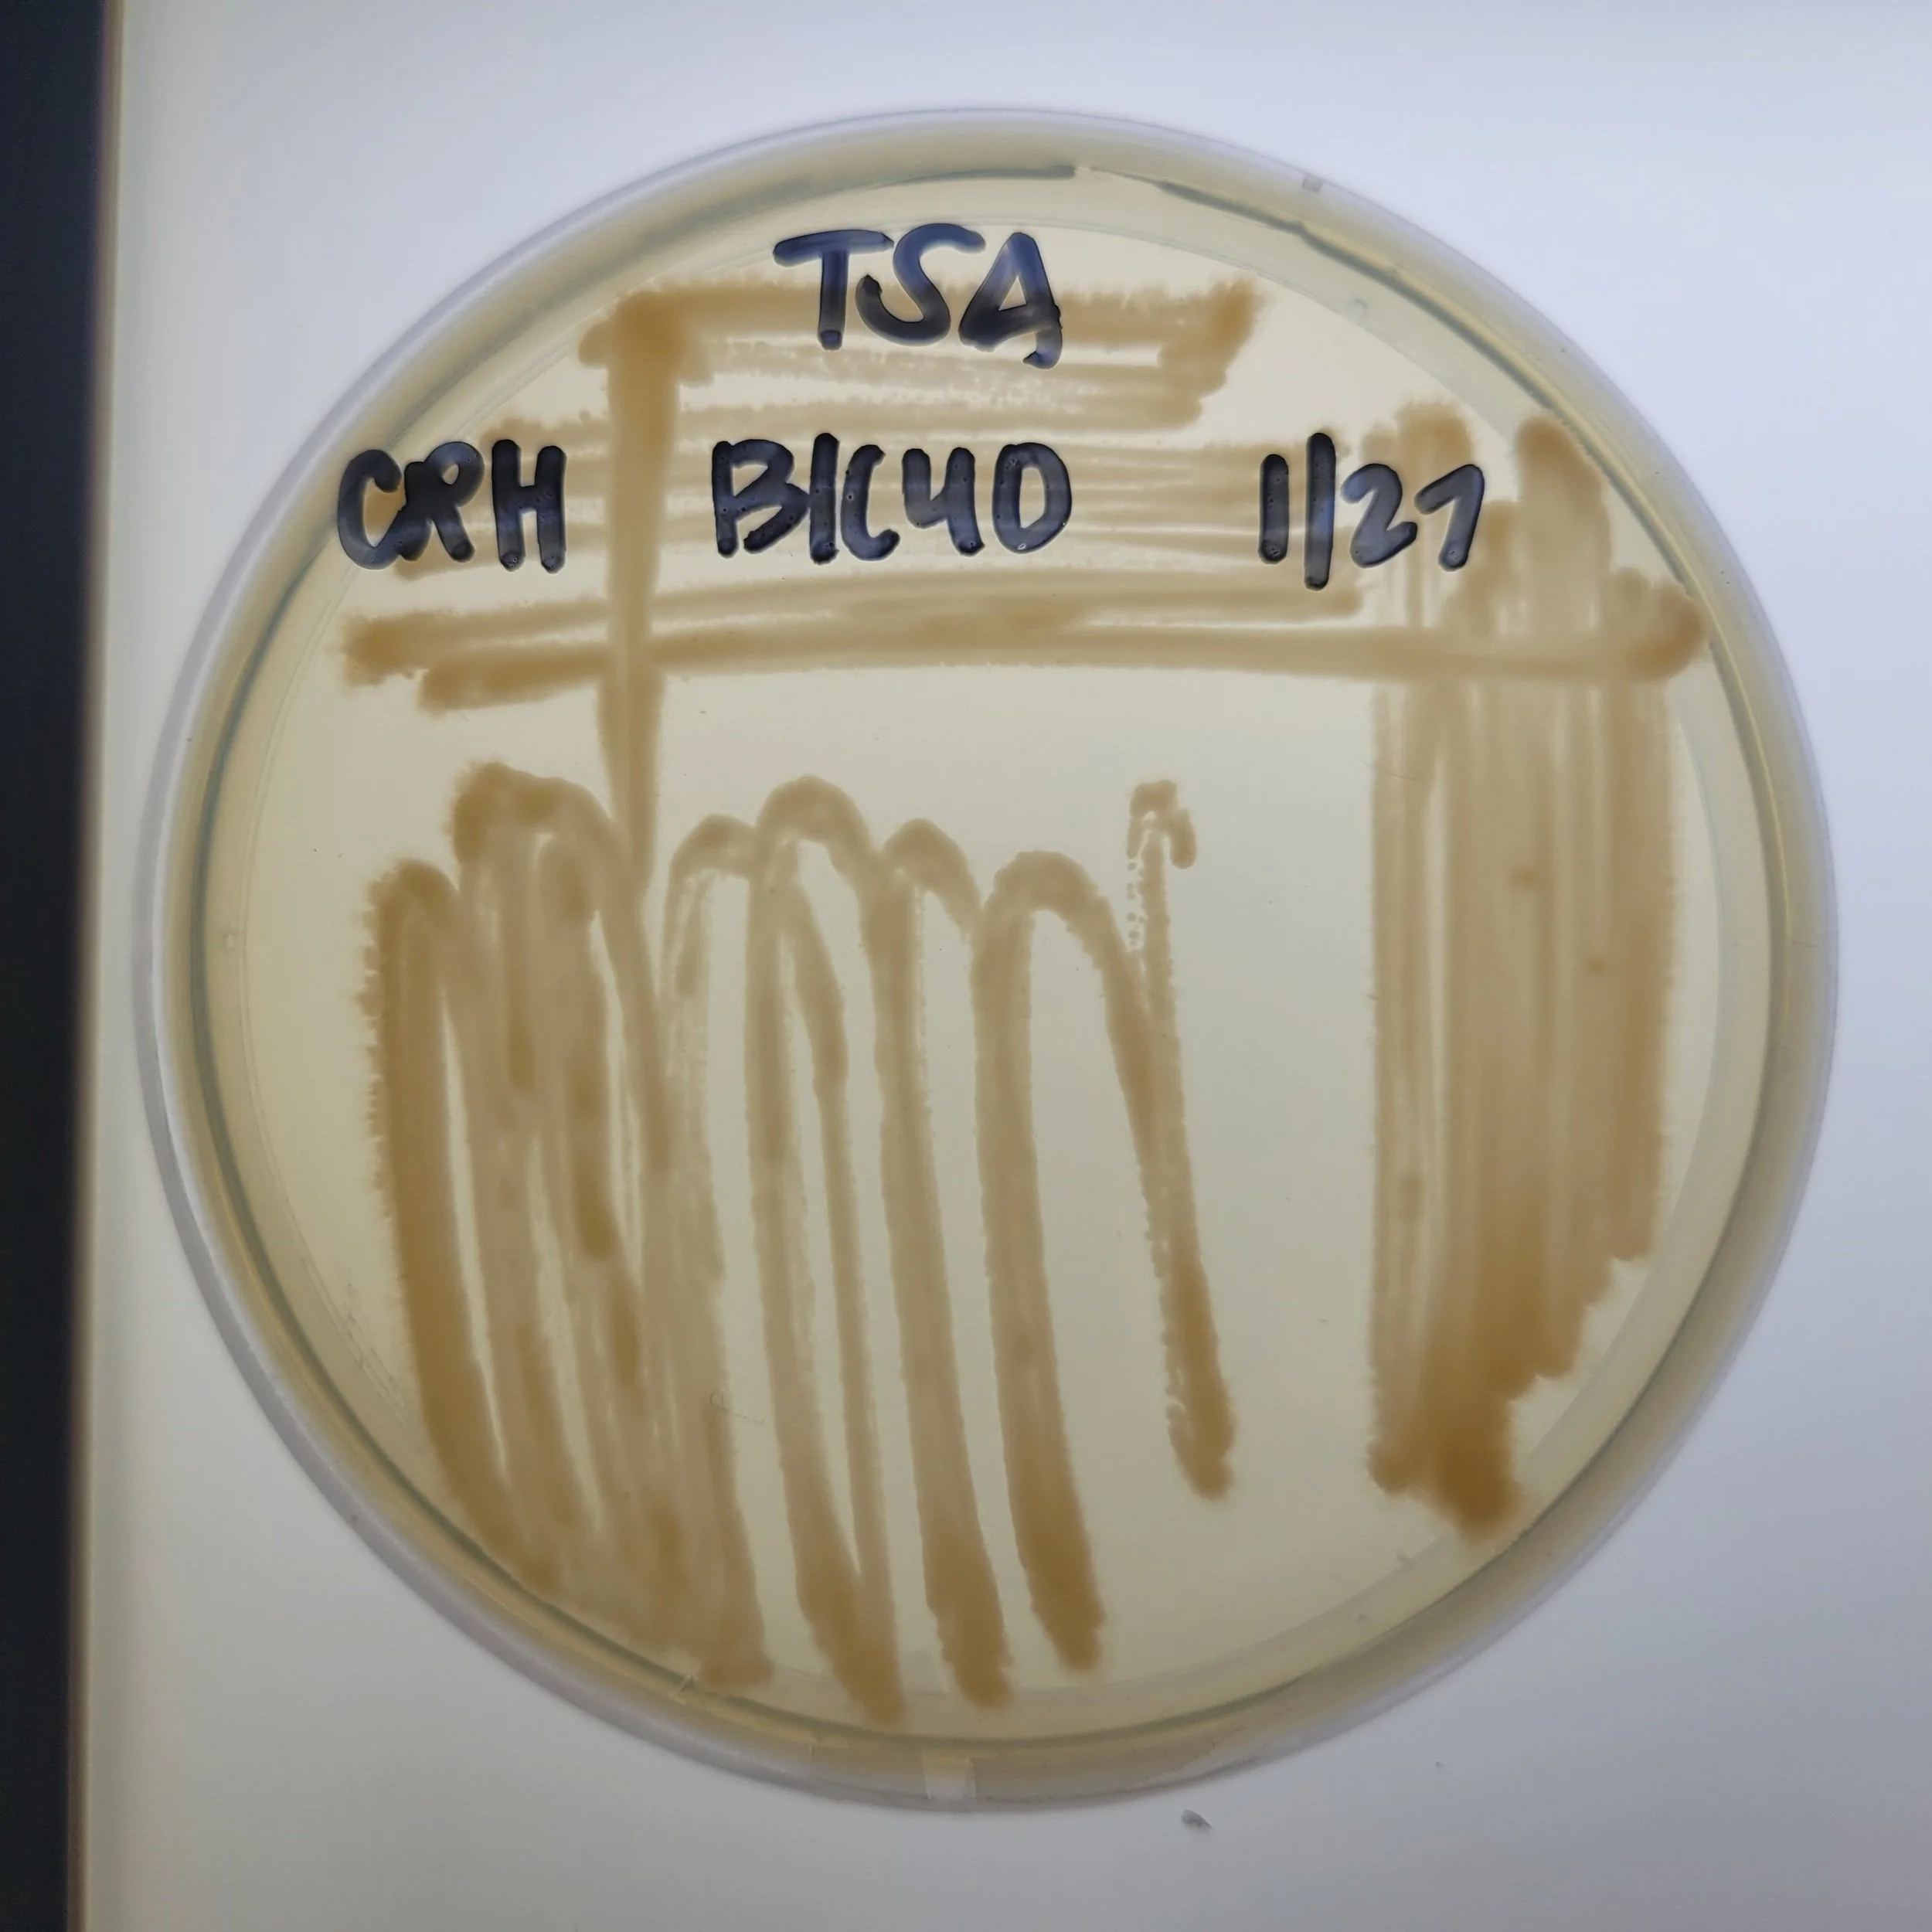

Haku Inoa: Lava Cave Microbes Naming Campaign
In the Hawaiian tradition, haku inoa means to compose a name, and given names carry great significance. From inoa hoʻomanaʻo (names based on a memory or event) to inoa hōʻailona (names based on physical features or omens), these etymologies are often also seen in the composition of contemporary scientific names, such as for Ceratocystis huliohia and Ceratocystis lukuohia, the fungal pathogens responsible for Rapid ʻŌhiʻa Death.
Since 2018, ʻĀina-Informatics Network partner classrooms have generated countless gigabases of genomic data towards reconstructing the whole genomes of lava cave microbes. To honor the many collaborations that have contributed to the completion of these genome assemblies, we are offering any participating school the opportunity to propose a name for any of the novel species reported to date by this project.
Meet the Microbes
BL16A
Proposed name: Bradyrhizobium prioriisuperbiae (St. Andrew’s Schools)
Sequenced by: St. Andrew’s Schools (2018)
Isolated from Kaūmana Cave.
K61*
Proposed name: Brennaria ulupoensis (Kaleomanuʻiwa Wong, Kauluakalana)
Sequenced by: ʻIolani School (2020).
Isolated from the loʻi at Ulupō Nui.
BL16E
Proposed name: Paraflavitalea speifideiaquila (Hawaiʻi Baptist Academy)
Sequenced by: Hawaiʻi Baptist Academy (2020)
Isolated from Kaūmana Cave.
BL84
Unnamed species in the genus Bosea.
Sequenced by: Moanalua High School (2022), Hawaiʻi Preparatory Academy (2022), Parker School (2022), Kealakehe Teacher Workshop (2022)
Isolated from Kaūmana Cave.
BIC-8F
Unnamed species in the genus Cupriavidus.
Sequenced by: Moanalua High School (2019), Kamehameha Schools Hawaiʻi (2023)
Isolated from a cave in Kīlauea caldera.
BIC-9C
Unnamed species in the genus Pseudomonas.
Sequenced by: Hawaiʻi Baptist Academy (2020)
Isolated from a cave in Kīlauea caldera.
BIC-5C-1
Unnamed species in the genus Paenibacillus.
Sequenced by: ʻIolani School (2019)
Isolated from a cave in Kīlauea caldera.
Y38-1Y*
Unnamed species in the genus Sphingomonas.
Sequenced by: ʻIolani School (2020), Hawaiʻi Baptist Academy (2020)
Isolated from a hypersaline pond on San Salvador Island, Bahamas.
BIC-40
Unnamed species in the genus Rhodococcus.
Not yet sequenced.
Isolated from a cave in Kīlauea caldera.
*Novel species sequenced by ʻĀina-Informatics Network students that were isolated from environments other than lava caves.
scientific Naming guidelines
In the system of binomial nomenclature, a scientific name comprises two parts: the genus and the species. More often than not, a newly reported species will be placed inside an existing genus, so only the species name or epithet needs to be proposed.
The name must be unique.
The name can’t be rude!
You don’t name a species after yourself! However, you can propose a name to honor another individual.
The name can be rooted in any language, but all proposed names will undergo revision to conform to Latin grammatical rules.
There is a lot of room for creativity when naming a new species. For example, you can highlight its appearance, habitat, function or behavior. Or you can pay homage to a place, a person or an event. Feel free to incorporate humor and fun!
To learn more about the process of finding and confirming a new bacterial species, head over to Dr. Stuart Donachie’s full blog post Growing and Naming a New Bacterial Species.